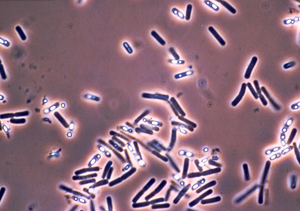
Bakterien: chlorierte Seide vernichtet schnell (Foto: pixelio.de/Christa Nöhren)

Chlorierte Seide tötet Bakterien
Krankheitserreger innerhalb von zehn Minuten unschädlich
![]() |
Bakterien: chlorierte Seide vernichtet schnell (Foto: pixelio.de/Christa Nöhren) |
Ohio (pte001/22.03.2012/06:00) Gewöhnliche Seide kann in eine Bakterien tötende Maschine verwandelt werden. Dazu haben Forscher vom Ohio Air Force Research Laboratory http://www.wpafb.af.mil/AFRL einen Stoff entwickelt, der Krankheit verursachende Keime in Minutenschnelle abtötet. Das geht aus einer neuen Studie hervor, die im Journal of the American Chemical Society http://bit.ly/8uhXPK präsentiert wurde.
Ähnlich Haushaltsbleichmittel
Obwohl Mikroben-zerstörende Chemikalien bei Textilwaren aus Baumwolle, Polyester, Nylon und Kevlar zum Einsatz kommen, sind diese gegen widerstandsfähigere Sporen nur wenig effektiv. Bestimmte Bakterien, wie der Anthrax-Erreger Bacillus anthracis, können sich festsetzen und sowohl Hitze als auch Strahlung, Antibiotika und andere Umstände überleben.
Forscher haben inzwischen jedoch eine chlorierte, in eine Lösung getränkte Form von Seide entwickelt, die einer Haushaltsbleichmittel ähnlichen Substanz ähnelt. Die Seide ist davor eine Stunde lang behandelt und anschließend getrocknet worden. Innerhalb von zehn Minuten konnte sie schließlich alle Bakterien töten.
Vielseitige Verwendung
"Abgesehen von den Aktivitäten der chlorierten Seide, die wir für die Studie vorbereitet haben, können Seide-Chlor-Materialien auf verschiedenste Arten Verwendung finden", so Studienleiter Rajesh R. Naik. "Dazu gehört beispielsweise das Herausfiltern von giftigen Substanzen im Wasser."
(Ende)| Aussender: | pressetext.redaktion |
| Ansprechpartner: | Rebecca Temmel |
| Tel.: | +43-1-81140-300 |
| E-Mail: | rtemmel@pressetext.com |
| Website: | www.pressetext.com |